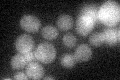
YBR125C
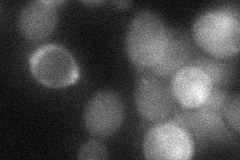
YBR125C

View description
Cytoplasmic type 2C protein phosphatase; identified as a high-copy number suppressor of the synthetic lethality of a cnb1 mpk1 double deletion; overexpression decreases high-osmolarity induced Hog1p phosphorylation and kinase activity
Localization:
Intensity:
Fold change:
Significance:
-
C’ GFP library in SD
below threshold17.14 -
N' NOP1pr-GFP in SD

cytosol71.4753 -
N' TEF2pr-mCherry in SD

cytosol84.5052 -
N' NATIVEpr-GFP in SD

below threshold24.2706 -
N' TEF2pr-VC and Cyto-VN in SD
cytosol35.6805 -
C’ GFP library in SD+DTT

cytosol19.151.11No -
C’ GFP library in SD+H2O2

cytosol19.791.15No -
C’ GFP library in Starvation Media

cytosol28.451.65No -
C’ GFP library on the background of Pup2-DaMP

below threshold -
C’ GFP library on the background of CCT mutant

below threshold17.3771.01379No
